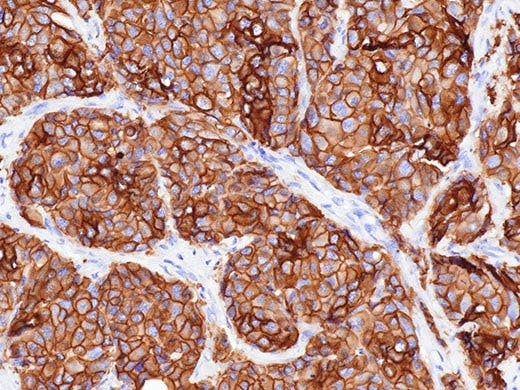
Un rendu fidèle des couleurs

Caméra numérique pour microscope DP23
Caméra couleur CCD 6,4 mégapixels. Images en direct Full HD à 60 images par seconde. Compatible avec la monture C standard. USB 3.1 Gen1 (compatible avec USB 3.0). Comprend le logiciel d'imagerie cellSens Entry. *Nécessite une monture C et un adaptateur 0,5-1,0X (0,5X recommandé)

DP23 Caméra numérique pour microscope
Caméra numérique haute définition pour microscope de laboratoire
Conçue pour la microscopie de routine dans le domaine clinique et des sciences de la vie et facile à utiliser, la caméra numérique DP23 combine des fonctions intelligentes et une fidélité chromatique exceptionnelle pour produire des images de haute qualité.
Une caméra de microscope très rapide
Capturez rapidement des images offrant le niveau de détail requis pour la plupart des applications d’imagerie en sciences de la vie.
- Images haute définition de 6,4 mégapixels à 30 ips
- Partage pratique d’images en local et à distance dans le cadre de conférences et de consultations
- Images en temps réel à 64 ips en HD intégrale

Un rendu fidèle des couleurs
La caméra DP23 assure une reproduction des couleurs d’une grande fidélité sur votre écran d’ordinateur.
- Avec ses profils ICC dédiés, vos échantillons s’affichent dans leurs couleurs authentiques
- Les principaux fluorophores utilisés en sciences de la vie apparaissent comme vous l’attendiez
- Utilisez la caméra avec la source de lumière à LED True Color d’Olympus et le microscope BX53 pour un système complet aux couleurs optimisées.
Une caméra de microscope avec un grand champ de vision
Observez une plus grande portion de votre échantillon grâce à un champ de vision incroyablement grand de FN25.
- Les images sont parfaitement planes et nettes du centre à la périphérie
- Combinez la caméra avec nos tout derniers composants optiques, comme les objectifs X Line et un adaptateur conçu pour l’obtention d’un grand champ de vision, afin d’en maximiser les capacités.
* Votre système de microscope doit être compatible avec un indice de champ (FN) de 25.


Partagez facilement les images prises avec votre caméra de microscope
Optimisez l’efficacité de vos collaborations. Toutes vos données essentielles (images, annotations et mesures en temps réel) peuvent être facilement affichées et partagées ensemble localement ou à distance.
- Partagez vos images et vos données à l’aide du logiciel cellSens et de la solution NetCam ou de la fonction de partage d’images à distance* au moyen du module autonome de commande de caméra.
- Un seul clic suffit pour lancer le partage d’images
- Conformité aux normes NIST et GDPR et prise en charge du logiciel antivirus pour un partage protégé
* La fonction de partage à distance et l’antivirus sont vendus en option.
Le logiciel DP23 n'est pas destiné à un usage diagnostique.
Technologies appliquées
Une caméra de microscope intelligente
- Le système « Olympus Smart Image Averaging » (OSIA) supprime le bruit et les artefacts tout en maintenant une fréquence d’images rapide.
- La fonction « Focus Peaking » vous permet d’identifier les régions de l’échantillon se trouvant dans le plan focal.
- Le mode « High Contrast » facilite l’acquisition des images et assure un rapport signal sur bruit élevé, de sorte que vous pouvez capturer des images de haute qualité d’échantillons à faible signal en microscopie en lumière polarisée et en fluorescence.
- La fonction « Fast Live » permet d’obtenir une fréquence d’images élevée et constante lors d’une exposition prolongée.


.

Une caméra de microscope facile à utiliser
- Une interface logicielle simple et intuitive vous permet d’acquérir des images en un seul clic pour un travail efficace
- Fixez le module autonome de la caméra à l’arrière de votre moniteur pour dégager de l’espace sur votre bureau.
- Branchez la caméra sur le port USB 3.1* de votre ordinateur, et elle est prête à l’emploi ; aucun adaptateur secteur n’est requis.
* USB 3.1 est compatible avec USB 3.0.
Caractéristiques techniques
- 1/1.8 pouce CMOS couleur
- 2 × 2
Max.58 ips à 2072 × 2072 (carré)
Max.60 ips à 1920 × 1080 (pleine HD) *1
CPU: Intel® Xeon, Intel® Core i5, i7, i9
RAM: 8GB
Recommended:
- 6 or more physical CPU cores
- 16GB RAM (8GBx2 : dual channel)
*1 Frame rate may decrease depending on the condition of your PC and/or software. It is recommended that you use a dual-channel memory configuration for your PC.
*2 USB 3.1 Gen1 is compatible with USB 3.0.
Microsoft and Windows are registered trademarks of Microsoft Corporation in U.S. The terms HDMI and HDMI High-Definition Multimedia Interface, and the HDMI Logo are trademarks or registered trademarks of HDMI Licensing Administrator, Inc. in the United States and other countries. All brand names or production names described in this web site are trademarks or registered trademarks of relevant owners.
Ressources
Livre blanc
Blogue
Vidéos
Ressources produit
Standalone module is not available in China.